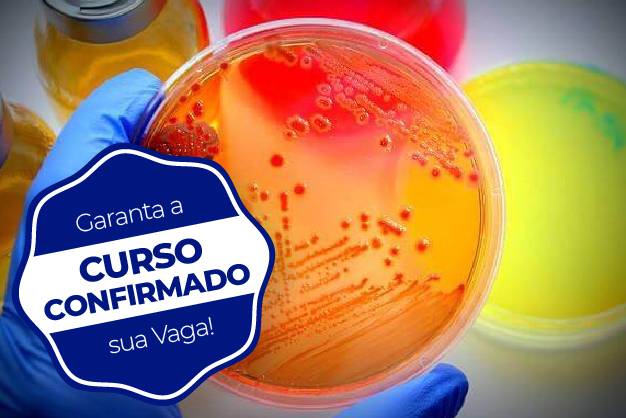

A Unijuí vai dar início, nesta sexta-feira, dia 02 de outubro, na Especialização em Microbiologia Laboratorial. Ainda é possível se inscrever ao curso, acessando este link. Com a coordenação do professor Matias Nunes Frizzo, é destinado para graduados em Biomedicina, Farmácia, Biologia, Medicina, demais profissionais da área da saúde e áreas afins.
Com os crescentes avanços na área da saúde, diversos novos exames e tecnologias têm sido integrados à rotina laboratorial. Neste sentido, este curso visa justamente capacitar seus estudantes nas mais novas técnicas microbiológicas bem como suas interpretações e correlações clínicas. Oferece aos seus estudantes aulas teóricas e práticas, a fim de instrumentalizar os estudantes a atuarem profissionalmente com um diferencial na qualidade de suas análises microbiológicas bem como em áreas associadas. Tem como objetivo qualificar os analistas clínicos da região, proporcionando oportunidade de aprendizagem e atualização em Microbiologia Laboratorial.
As aulas serão quinzenais, realizadas nos seguintes horários: sexta-feira, noite, das 19h às 22h. Sábado, manhã, das 08h às 12h e tarde, das 13h às 18h. Egresso da Unijuí tem desconto de 15% na mensalidade. Mais detalhes na página da Especialização.